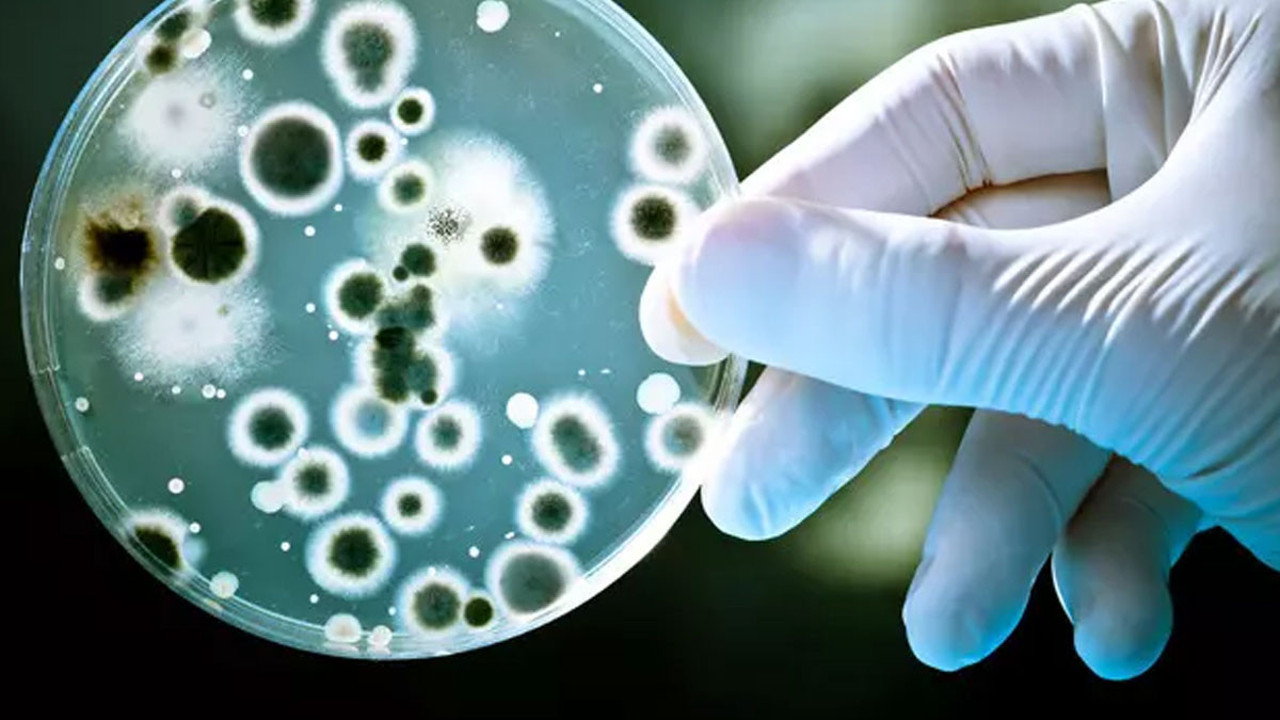
DSÖ'den dünyayı korkutan uyarı: 40 milyon kişi hayatını kaybedebilir

Pandeminin ardından yapılan uyarılar herkes tarafından takip edilirken, bilim insanlarından korkutan bir uyarı daha geldi.
Yapılan araştırmalara göre, antibiyotiklere dirençli bakteriler güçlendi. Bilim insanları hastane mikrobu olarak da adlandırılan bu bakteriler sebebiyle 2050 yılına kadar yaklaşık 40 milyon kişinin yaşamını yitireceğini ileri sürüldü.

40 MİLYON KİŞİ HAYATINI KAYBEDECEK
NTV'de yer alan habere göre; Süper Bakteri krizi derinleşiyor. 2050 yılına kadar yaklaşık 40 milyon kişi hiçbir ilaç fayda etmeyeceği için ölecek. Mikrobiyoloji uzmanlarının oluşturduğu araştırma ekibi 204 ülkede 30 yıllık hasta kayıtlarını mercek altına aldı.
‘VAKALAR YÜZDE 70 ARTACAK’
Bu Antibiyotiğe dirençli bakteriler sebebiyle hayatını kaybedenlerin 70 yaş üstü hastalarda yüzde 80 arttığı görüldü. Lancet dergisinde yayınlanan araştırmada gelecek 25 yıl içerisinde antibiyotiğe dirençli enfeksiyon vakalarının yüzde 70 oranında artacağı söylendi. Bu durum bilinen tüm ilaçlar ve antibiyotikler kullanıldığı halde 39 milyon kişinin hayatını kaybedeceği anlamına geliyor.

KAN ZEHİRLENMESİ GİBİ CİDDİ KOMPLİKASYONLARA NEDEN OLUYOR
Antibiyotiğe karşı direnç gösteren MRSA olarak da adlandırılan Staphylococcus aureus, enfeksiyonu sebebiyle hayatını kaybedenlerin 2021 yılları arasında 2 kattan fazla artarak 130 bini aştığı ifade edildi.
Özellikle yoğun bakımdaki hastalarda kan zehirlenmesi gibi ciddi komplikasyonlara, hatta ölüme yol açabilen bu bakterilerin en güçlü antibiyotiklerle bile zorlukla yok edilebildiği ifade ediliyor.

GEREKSİZ ANTİBİYOTİK KULLANMANIN ZARARLARI
Gereksiz antibiyotik kullanımının bakterilerin direnç kazanmasını hızlandırdığı bilinirken, bilim insanları uyarıda bulunuyor. Antibiyotiğe dirençli bakterilerin güçlenmesiyle en basit enfeksiyonlar bile ölümcül hale gelebilecek.